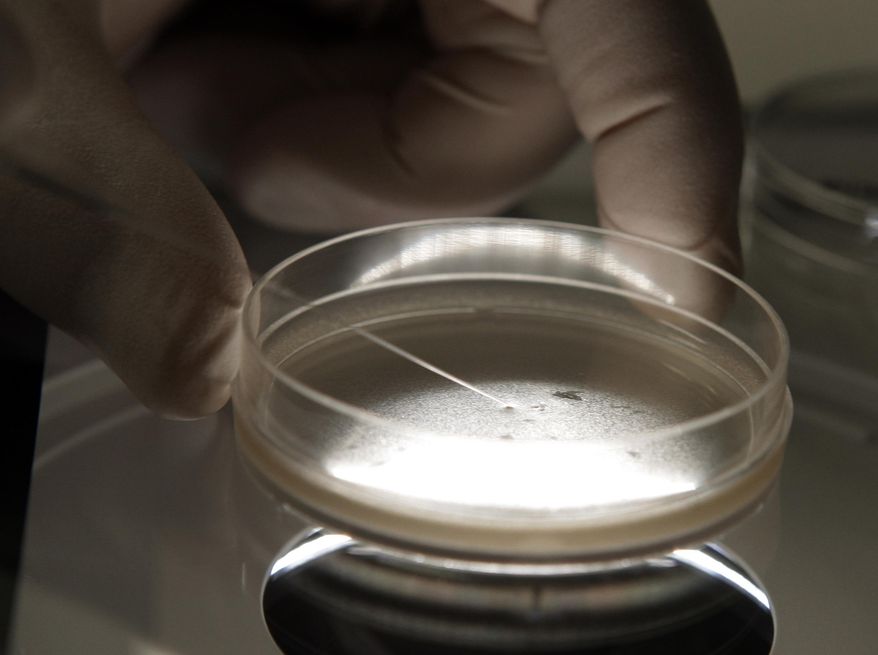
FILE - In this Oct. 22, 2008 file photo, a researcher examines human embryonic stem cells with a microscope in Michigan. On Thursday, Dec. 20, 2018, the Centers for Disease Control and Prevention reported that at least 12 patients in three states _ Florida, Texas and Arizona _ became infected after getting embryonic stem cell injections for problems like joint and back pain. (AP Photo/Paul Sancya, File)

FILE - In this Oct. 22, 2008 file photo, a researcher examines human embryonic stem cells with a microscope in Michigan. On Thursday, Dec. 20, 2018, the Centers for Disease Control and Prevention reported that at least 12 patients in three states _ Florida, Texas and Arizona _ became infected after getting embryonic stem cell injections for problems like joint and back pain. (AP Photo/Paul Sancya, File)
Featured Photo Galleries
Military parade celebrates Army’s 250th
Cheers and chants rang out Saturday from a crowd of thousands as soldiers manned modern and historic tanks and aircraft for the Army’s 250th anniversary celebration in the District.
Ovi scores goal 890, Caps lose to Sabres 8-5
Alexander Ovechkin scored goal number 890, but the Washington Capitals fell short, losing to the visiting Buffalo Sabres Sunday afternoon 8-5 at Capital One Arena in Washington D.C., March 30, 2025 (Photos for the Washington Times.)
Hegseth joins veterans, generals to mark 80th anniversary of battle of Iwo Jima
A handful of retired Marines – all in the late 90s or over 100 — joined Defense Secretary Pete Hegseth and Japan’s Prime Minister Takeru Ishida on Saturday to mark the anniversary of one of the bloodiest battles of World War II in the Pacific that ended 80 years ago this week.